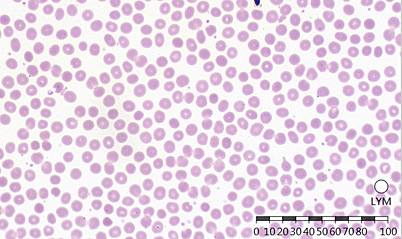

Vision Hema® Ultimate Гематологический сканер-анализатор
Арт. 4984
Характеристики
Страна происхождения
—
Австрия
Эффективное решение для больших лабораторий
Цена по запросу
Идентификация и преклассификация лейкоцитов
-
Базофилы
-
Эозинофилы
-
Промиелоциты
-
Миелоциты
-
Метамиелоциты
-
Бласты
-
Палочкоядерные нейтрофилы
-
Сегментоядерные нейтрофилы
-
Лимфоциты
-
Моноциты
-
Реактивные лимфоциты
-
Эритробласты
Анализ эритроцитов
-
Размер
-
Цвет
-
Форма
-
Включения
Анализ тромбоцитов
-
Нормальные
-
Микро
-
Макро
Искусственный интеллект
Искусственный интеллект (ИИ) — вид алгоритмов/технологий, благодаря которым компьютеры способны учиться и решать интеллектуальные задачи, которые перед ними ставит человек. ИИ ускоряет процесс обработки и интерпретации данных, помогая эффективно выполнять сложные задачи, в том числе и такие, как анализ медицинских изображений.
Дополнительные модули:
Vision Extended RBC
Vision Extended PLT
Vision RET
Vision Body Fluids
Идентификация и пре-классификация клеток в жидкостях человека.
Административные модули:
Vision Manager
Vision Remote
Удаленное рабочее место.
Модули для консультации и обучения
Vision Suite
Vision Expertise
Клиническое применение
Последние разработки в области искусственного интеллекта решают задачи автоматизации цифровой микроскопии. Наши технологии улучшают диагностический процесс, сокращают время анализа, снижают субъективность полученных результатов. Благодаря им, повышается эффективность работы лаборатории и клинические микроскопические исследования переводятся на современные стандарты.
Vision Ultimate Cell Imaging Analyzer
-
Аппликационный модуль
-
Vision Hema
-
Дополнительные модули
-
Vision Extended RBC
-
Vision Extended PLT
-
Vision RET
-
Vision Body Fluids
-
Vision Malaria
-
Режим работы:
-
очередь, непрерывный и произвольный доступ, срочная проба, 24/7
-
Автоматическое сканирование
-
До 200 слайдов
-
Автоматическая загрузка слайдов
-
Сканирующий микроскоп
-
Персональный компьютер
-
Монитор
-
Управляющий тач-монитор
-
Встроенный считыватель штрих-кодов
-
Податчик иммерсионного масла
-
Объективы:
-
10x, 50x МИ, 100x МИ
-
Светлое поле
-
Освещение по Келлеру, LED
-
Двунаправленное подключение к ЛИС, LIS2-A2 (ASTM), HL7